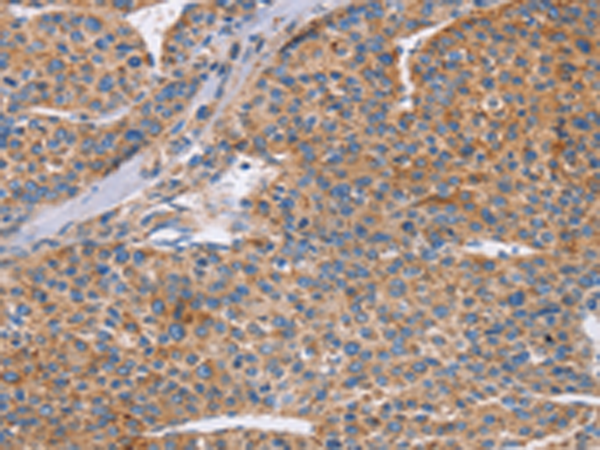

中文名稱:兔抗CDC7多克隆抗體
英文名稱: Anti-CDC7 rabbit polyclonal antibody
別 名: Hsk1; CDC7L1; HsCDC7; huCDC7
相關(guān)類別: 一抗
儲(chǔ) 存: 冷凍(-20℃)
宿 主: Rabbit
抗 原: CDC7
反應(yīng)種屬: Human, Mouse
標(biāo) 記 物: Unconjugate
克隆類型: rabbit polyclonal
技術(shù)規(guī)格
|
Background: |
This gene encodes a cell division cycle protein with kinase activity that is critical for the G1/S transition. The yeast homolog is also essential for initiation of DNA replication as cell division occurs. Overexpression of this gene product may be associated with neoplastic transformation for some tumors. Multiple alternatively spliced transcript variants that encode the same protein have been detected. |
|
Applications: |
ELISA, IHC |
|
Name of antibody: |
CDC7 |
|
Immunogen: |
Synthetic peptide of human CDC7 |
|
Full name: |
cell division cycle 7p |
|
Synonyms: |
Hsk1; CDC7L1; HsCDC7; huCDC7 |
|
SwissProt: |
O00311 |
|
ELISA Recommended dilution: |
2000-10000 |
|
IHC positive control: |
Human liver cancer and Human colon cancer |
|
IHC Recommend dilution: |
100-300 |
購(gòu)物車
購(gòu)物車 幫助
幫助
 021-54845833/15800441009
021-54845833/15800441009
